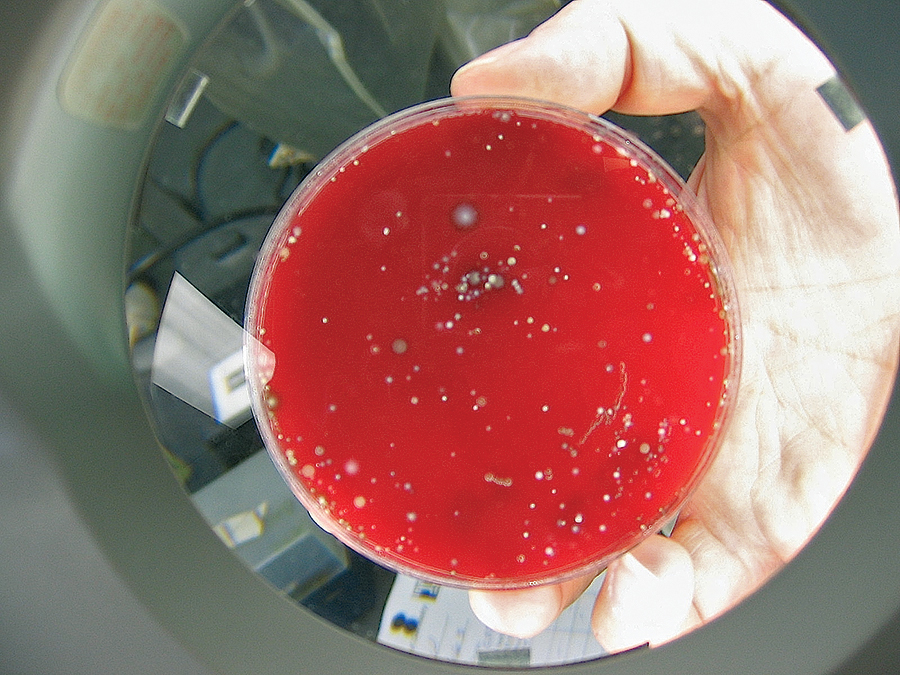
Figure 18. Blood agar plate with bacteria from a subgingival plaque sample after they were cultured under anaerobic conditions in an incubator.

Periodontal Inflammation: Simplified
Inflammation has been studied since ancient times. It was observed that as a result of irritation, injury or infection, tissues throughout the body react by increased redness (rubor), swelling (tumor), heat (calor), and pain (dolor).1 Today, we know that inflammation is a process driven by cells responding to signals from the body to fend off … Read more